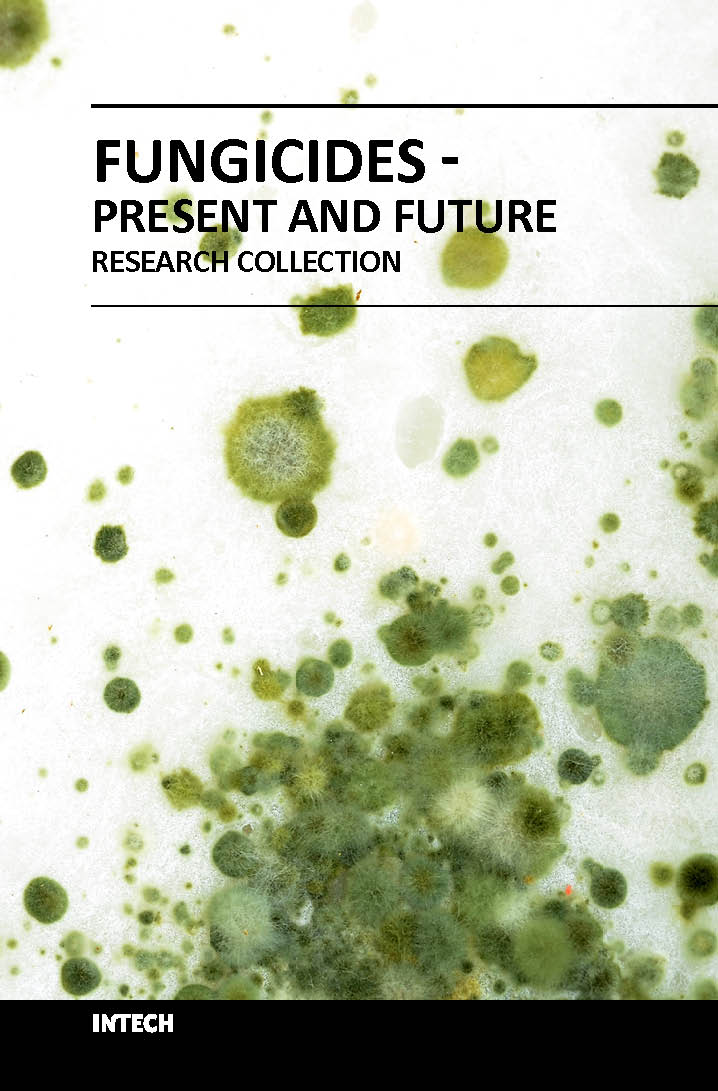
Fungicides present and future (hb 2018)

Safe and effective fungicides are crucial in horticulture and agriculture, as well as in medical and veterinary contexts. This book showcases recent advances, presents and evaluates current knowledge, and discusses challenges and opportunities for future research. Part one showcases integrated plant disease management approaches draws from around the world. Chapters explore the detection of fungicide resistance and approaches to the chemical control of peanut diseases. Part two offers eight studies of fungicides today. Contributors explore topics including the effects of fungicides on animals, toxicology of fungicides, and the influence of fungicide residue on wine quality. Part three focuses on beneficial and harmful aspects of fungicides, and includes contributions on resistance to botryticides and the molecular characterization of Carbendazim resistance in plant pathogens. Finally, part four reviews fungicides for plant and animal diseases. Contributions range across issues including naturally occurring antifungal agents, the use of fungicides and other antibiotics in aseptic plant cultures, and the use of Cu fungicides in vineyards and olive groves. This wide-ranging book will be useful for researchers as well as for professionals in the food industry seeking both current knowledge and new ideas.

| Specifications |
Descriptions |
| ISBN |
9789535120889 |
| Published Year |
2018 |
| Binding |
Hardcover |
| Subject |
Agriculture |
| Pages |
440 |
| Weight |
0.4 (In Kg) |
| Readership |
NA |